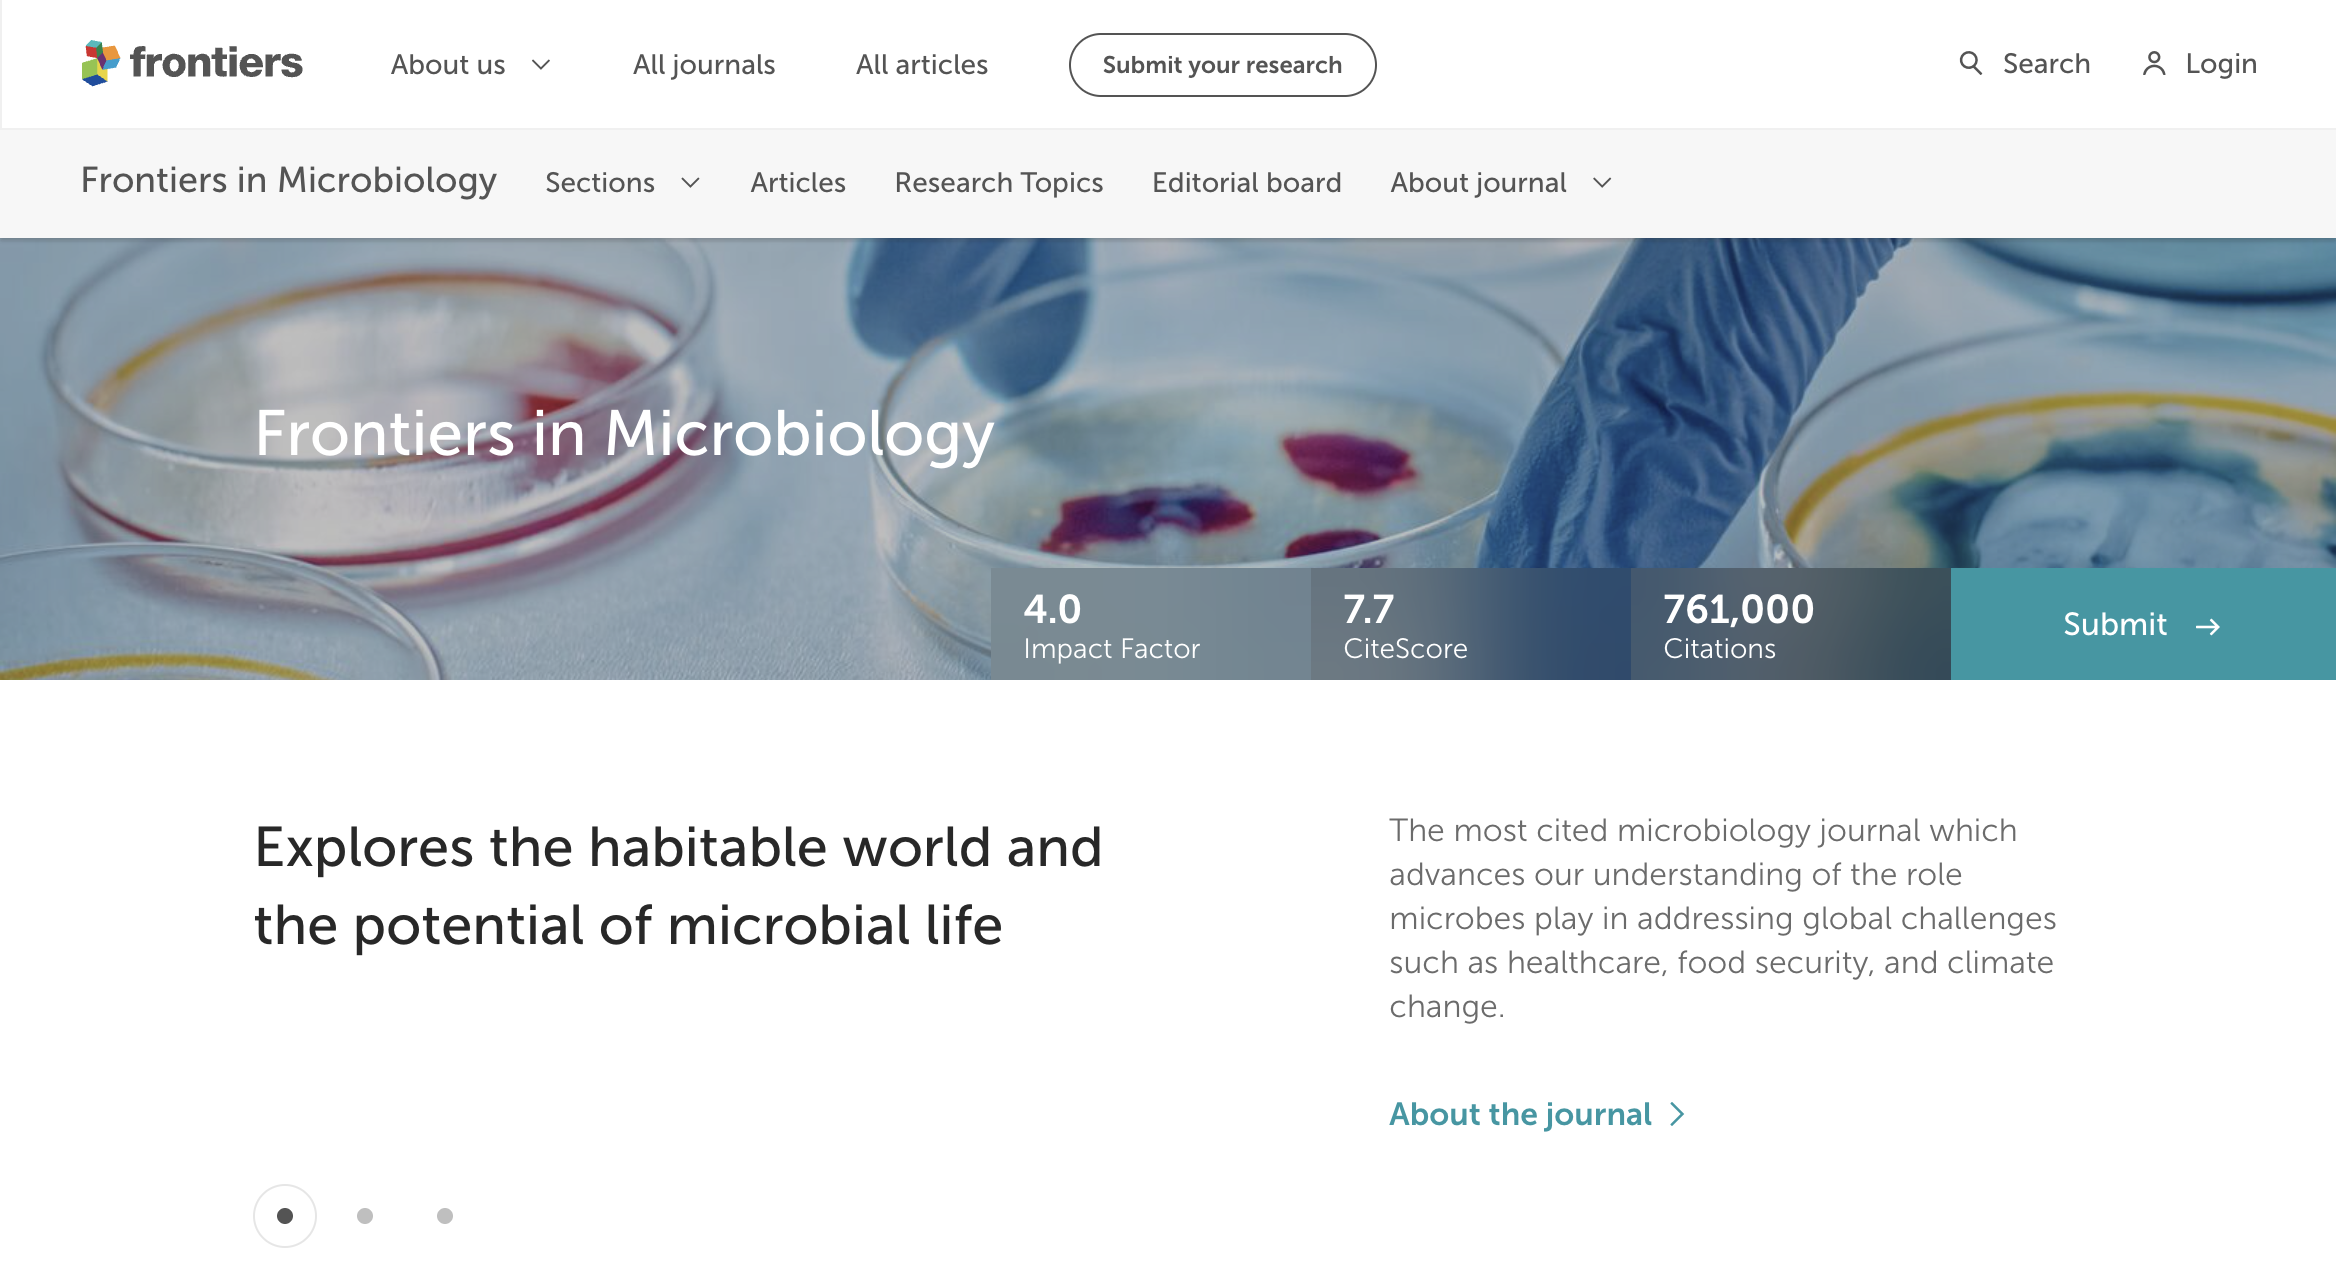

Gut Dysbiosis boleh menyebabkan toksin ke dalam darah, mengakibatkan perut tidak selesa, bacaan gula tidak stabil, mudah letih dan daya tahan badan makin lemah. Jika dibiarkan, ia boleh menjejaskan kesihatan menyeluruh tanpa disedari.
SUNNAHERBS PREBIOTIC COFFEE
Penyelesaian Semula Jadi Kopi Harian Untuk Kesihatan Usus, Diabetik & Tiga Serangkai.
Perhatian!!!
Tahukah Anda, Ramai Masih Minum Kopi Gula Putih Walaupun Sudah Berusia 40 Tahun Ke Atas? Kopi berasid tinggi + gula putih boleh menyebabkan usus rosak, kulit kusam, badan cepat lesu & otak makin lemah terutama golongan 35 hingga 50 tahun.
Masalah Ini Sering Diabaikan, Tetapi Jika Dibiarkan, Boleh Menyebabkan Risiko:
Sembelit kronik, kabur fikiran, diabetes, keradangan usus & Tiga Serangkai.

Sakit Perut & Kembung Setiap Pagi
Kopi biasa berasid tinggi boleh ganggu perut terutama jika diambil semasa perut kosong.

Gula Putih Dalam Kopi = Musuh Usus Senyap
Gula menyebabkan keradangan dalaman, sembelit & mikrobiom usus terganggu.

Atasi Usus Lemah, Badan Lesu & Tiga Serangkai
Bersama SUNNAHERBS PREBIOTIC COFFEE

Rasa Lesu & Kabur Fikiran Sepanjang Hari
Usus yang tidak sihat memberi kesan langsung kepada fokus dan tenaga otak.

Susah Buang Air & Tak Lawas
Kopi tanpa nutrien seperti prebiotik hanya melawaskan buat sementara tanpa rawat punca.
Setiap Pagi, Ramai Terus Minum Kopi Biasa Tanpa Sedar Ia Merosakkan Usus Mereka Perlahan-lahan.
Tukar sebelum terlambat.
Jika anda ada masalah di atas
Berkemungkinan Anda mengalami masalah
Makan ubat tahan sakit atau ubat sembelit bukan penyelesaian jangka panjang. Malah, jika dibiarkan, ia boleh menyebabkan keradangan usus, masalah imun, gangguan kulit & penurunan fungsi otak.
Usus Sihat, Hidup Lebih Berkualiti. Nikmati makanan tanpa rasa kembung, lawas setiap pagi, kulit makin bersih dan tenaga stabil sepanjang hari. Otak rasa segar dan badan kembali bertenaga.

Tapi Jika Dibiarkan... Perut akan makin sensitif. Makan apa pun rasa tak selesa. Bacaan Gula Naik, fikiran jadi serabut dan badan mudah penat. Akhirnya terpaksa jumpa doktor berkali-kali tanpa solusi sebenar.

Jika tidak dirawat, ia boleh menjejaskan kualiti hidup, menyebabkan stres, gangguan tidur, dan dalam jangka panjang, boleh meningkatkan risiko masalah kesihatan yang lebih serius.
Perhatian!!!
Gut Dysbiosis boleh berlaku Disebabkan...

Pemakanan tidak sihat seperti makanan pedas & berasid.

Gaya hidup tidak sihat, kurang bersenam & makan tidak teratur.

Tekanan (stress) yang menyebabkan asid perut berlebihan.

Jangkitan bakteria H. pylori dalam perut.

Pengambilan ubat tahan sakit secara berterusan.

Kekurangan probiotik yang membantu keseimbangan perut.
Ini Yang Anda Akan Alami Jika Masalah Gut Dysbiosis Dibiarkan Berlarutan…

Perut Semakin Sensitif & Mudah Sakit

Emosi Tidak Stabil, Mudah Cemas & Stres

Usus Bocor & Toksin Meresap Ke Dalam Darah

Gangguan Tidur & Badan Lesu Sepanjang Hari

Berat Badan Tak Stabil & Badan Semakin Lemah

Risiko Penyakit Kronik Seperti Diabetes & Radang Sistemik
Laporan Kajian
Kajian oleh Kajian Oleh British Journal of Nutrition Menemui Gut Dysbiosis Berkait Dengan Risiko Masalah Kognitif & Keradangan Sistemik.
Nature Reviews Gastroenterology & Hepatology pula menyatakan bahawa prebiotik terbukti menyokong keseimbangan mikrobiom usus, seterusnya membantu meningkatkan fungsi penghadaman, mood dan kesihatan otak.

Kajian juga oleh HARVARD MEDICAL SCHOOL
Gut Dysbiosis boleh menyebabkan ketidakseimbangan bakteria dalam usus, mengakibatkan perut kembung, sembelit, kurang selera makan dan kulit bermasalah. Jika dibiarkan,
ia boleh jejaskan penyerapan nutrien, buat badan cepat letih dan ganggu kestabilan emosi serta fokus harian. Sunnaherbs Prebiotic Coffee bantu pulihkan semula keseimbangan usus dari akar.
Anda Tak Perlu Risau Lagi INI SOLUSINYA
0
telah berjaya pulihkan masalah Gut Dysbiosis. Kami dah bantu ribuan pelanggan pulihkan sistem penghadaman, dan terima ratusan testimoni positif setiap bulan dari pengguna laman ini.
Masalah seperti sembelit, perut kembung, tiga serangkai kurang tenaga & kabur fikiran kini semakin pulih bila usus kembali sihat.
Memperkenalkan PRODUk berasaskan Prebiotik Delima

Pulihkan Masalah Gut Dysbiosis Dengan SUNNAHERBS PREBIOTIC COFFEE
Pilihan Kopi Harian Yang Dirumus Khas Untuk Menyokong Kesihatan Usus, Kurangkan Sembelit, Kembung Perut & Kulit Bermasalah Secara Semula Jadi!
Mengandungi Prebiotik Tumbuhan, Sucralose Mesra Diabetes & Serat Larut Air yang terbukti membantu keseimbangan mikrobiom usus dan menyokong penghadaman sihat.
Sunnaherbs Prebiotic Coffee diformulasikan dengan nutrien penting yang bantu keseimbangan bakteria usus tanpa kompromi rasa.
Berbeza dengan kopi biasa yang tinggi gula dan tiada manfaat usus. produk ini bebas gula putih & rendah asid!
Ia juga direka khusus untuk mereka yang berumur 35 tahun ke atas, yang mahu kekal cergas, lawas dan bebas masalah perut setiap pagi.

Risau GERD? Anxiety? Sukar Tidur Malam?
JANGAN RISAU
SUNNAHERBS Ada!
- Membantu seimbangkan semula bakteria baik dalam usus untuk sistem penghadaman yang lebih sihat
- Kurangkan rasa kembung, susah lawas dan perut tidak selesa setiap pagi
- Sokong kesihatan kulit dan otak melalui pemulihan sistem usus secara semula jadi
- Guna sucralose bebas kalori – sesuai untuk mereka yang ada masalah diabetes atau kawal gula
- Formulasi rendah asid – tidak ganggu perut seperti kopi biasa
- Sesuai diamalkan setiap hari untuk kesan jangka panjang kepada tenaga, imun & pencernaan

- Terbukti & Berkesan
- 8,000+ pengguna berpuas hati
- Bahan Asas Semulajadi
Lebih 8,000+ Telah Berjaya Atasi Dispesia Fungsional.
Kami Telah Terima Ratusan Ke Ribuan Feedback. Kami juga pilihan utama pengguna di Tiktok, Instagram & Facebook Sejak 2020! Kini Giliran Anda!
ATASI GUT DYSBIOSIS, SEMBELIT & BADAN LESU DENGAN SUNNAHERBS PREBIOTIC COFFEE!
KEBAIKAN SUNNAHERBS PREBIOTIC COFFEE
Bagaimana Sunnaherbs Bertindak & Mampu Pulihkan Usus Anda?
Prebiotik dari tumbuhan dalam Sunnaherbs bantu pembiakan bakteria baik, pulihkan mikrobiom usus & lancarkan sistem penghadaman secara semula jadi.
Sebelum Guna SUNNAHERBS

Perut kerap kembung, sembelit, kulit kusam, lesu & susah fokus akibat usus tidak sihat.
Selepas Guna SUNNAHERBS

Tiada lagi masalah kembung & lawas setiap pagi. Perut rasa ringan, bacaan gula stabil & badan kembali bertenaga.
Sunnaherbs bantu pulihkan keseimbangan usus, tingkatkan imun, tenaga & pencernaan – secara selamat dan konsisten.

Prebiotik tumbuhan dalam Sunnaherbs membantu seimbangkan bakteria baik dalam usus, menyokong sistem penghadaman yang sihat dan lawas. Sucralose bebas kalori pula menggantikan gula putih bagi mengurangkan keradangan dalaman tanpa naikkan paras gula darah.
Hakikatnya, Gut Dysbiosis boleh menjejaskan kualiti hidup tanpa disedari. Ia menyebabkan badan mudah letih, fokus terganggu, ganggu bacaan darah dan emosi tidak stabil akibat ketidakseimbangan usus yang berpanjangan.
LIHAT FEEDBACK mereka YANG TELAH gunakan NATTOFLUX!

Diperkaya dengan bahan semulajadi
Disokong Kajian Klinikal & Digunakan Secara Konsisten Oleh Pengguna Berumur 35 Tahun Ke Atas, Sunnaherbs Prebiotic Coffee Diformulasikan Dengan Bahan Yang Terbukti Menyokong Kesihatan Usus Secara Semula Jadi.
Prebiotik Tumbuhan
Membantu pembiakan bakteria baik dalam usus untuk sistem penghadaman yang lancar & lawas.
Sucralose (Bebas Kalori)
Pemanis selamat tanpa gula putih tidak naikkan gula darah dan mesra untuk penghidap diabetes.

Serat Larut Air
Membantu pergerakan usus lebih teratur dan menyokong proses detoks secara semula jad
Ekstrak Kopi Rendah Asid
Lemak, wangi & lebih mesra perut berbanding kopi biasa tiada gangguan keasidan selepas minum.
Gabungan Prebiotik & Serat dalam Sunnaherbs bantu pulihkan mikrobiom usus, tingkatkan penyerapan nutrien, dan kurangkan simptom seperti sembelit, kembung serta keletihan kronik.
Sesuai diamalkan setiap hari untuk menyokong tenaga, emosi, kulit & fokus anda secara berterusan.
kajian Demi Kajian Jurnal Antarabangsa
Ini kajian yang dibuat oleh Pakar dari pelbagai university serata dunia.

Journal of Functional Foods
Kajian mendapati Prebiotic membantu meningkatkan sistem penghadaman dan mengurangkan simptom GERD.
Frontiers in Microbiology
Probiotik terbukti mengurangkan asid perut & mengawal bakteria H. pylori.

International Journal of Molecular Sciences
Prebiotik membantu meningkatkan keseimbangan bakteria baik & menyokong sistem pencernaan.

Journal of Medicinal Food
Prebiotik membantu mengurangkan keradangan dalam perut.
Ini kata mereka
JANGAN PERCAYA APA YANG KAMI KATA, LIHAT FEEDBACK PENGGUNA SEBENAR DIBAWAH
Anda pun mesti nak result yang macam ni kan? Jadi apa tunggu lagi. Cepat dapatkan sekarang!
Mendapat kelulusan Kementerian Kesihatan Malaysia
Lulus Ujian makmal Secara Klinikal
Sunnaherbs Prebiotic Coffee diformulasi mengikut standard keselamatan makanan dan telah melalui ujian makmal bebas. Bebas dari logam berat, bahan kimia merbahaya, steroid dan dadah terlarang.

takut jika TIDAK BERKESAN?
Jika tak berkesan macam mana?
Jangan risau
Kami faham, anda mungkin dah cuba pelbagai cara untuk atasi masalah sembelit, kembung, bacaan gula dalam darah, cepat letih dan susah fokus dari minum pelbagai teh, cuba supplement lain, sampai bergantung pada ubat tahan sakit.
Sebab itu kami syorkan Sunnaherbs Prebiotic Coffee! Solusi sihat dan selamat untuk usus anda!

*** Untuk elakkan ada pihak yang mengambil kesempatan tentang REFUND & RETURN policy ini, kami terpaksa meletakkan beberapa syarat mudah. Boleh rujuk T&C diruangan FAQ diawah.
Bagaimana cara guna?
Hanya 1 Cawan Sehari
1. Bancuh Dalam Air Panas
Ambil satu sachet Sunnaherbs, koyakkan dan bancuh dalam 150ml air panas (bukan mendidih). Kacau hingga larut sepenuhnya. Sedia untuk diminum.
2. Minum Setiap Pagi Ketika Sarapan
Waktu terbaik adalah ketika sarapan untuk bantu sistem penghadaman bersedia dan menyerap nutrien dengan lebih baik sepanjang hari.
3. Konsisten Setiap Hari Untuk Kesan Maksimum
Amalkan 1 cawan setiap hari. Boleh juga diminum pada waktu petang jika perlu tambahan tenaga atau lawas. Kesan optimum biasanya dapat dilihat dalam 7–14 hari penggunaan konsisten.
Takut dah bayar barang tak sampai?
JANGAN RISAU
Barang Anda Pasti Sampai!
Jangan risau, anda boleh order dahulu, dah sampai depan rumah anda baru bayar (COD). COD Ninjavan 100% jaminan pulangan wang!

- Terbukti & Berkesan
- 10,000+ pengguna berpuas hati
- Tiada kesan sampingan
Khas pembelian di website ini
KHAS UNTUK YANG BUAT PEMBELIAN DI WEBSITE INI, PIHAK HQ SUNNAHERBS NAK BAGI SPECIAL OFFER

tempah sekarang
Pilih Pakej Sunnaherbs Prebiotic Coffee Di Bawah
Kami susun pakej berdasarkan tempoh penggunaan agar anda dapat hasil paling berkesan. Untuk kesan jangka panjang pada usus, tenaga dan kulit – kami syorkan terus ambil Pakej 4 Kotak (Percuma 1 Kotak).

5 KOTAK (4 + 1 PERCUMA)
RM195
KEGUNAAN SEHINGGA 3 BULAN
- Penjimatan Besar: Jimat RM305
- Free Postage (bayaran online)
- Boleh Bayar Masa Sampai (COD)

3 KOTAK – PAKEJ SIHAT
RM139
Kegunaan Sehingga 7 Minggu
- Penjimatan: Jimat RM151
- Free Postage (bayaran online)
- Boleh Bayar Masa Sampai (COD)

1 KOTAK PAKEJ TRIAL
RM59
Kegunaan Sehingga 2 Minggu
- Penjimatan: Jimat RM41
- Free Postage (bayaran online)
- Boleh Bayar Masa Sampai (COD)
FAQ - Soalan Lazim
Soalan Lazim & Kerap Ditanya Tentang Sunnaherbs
Ya, Sunnaherbs Prebiotic Coffee menggunakan formulasi rendah asid dan mesra perut. Ia tidak mengganggu perut seperti kopi biasa dan sesuai diamalkan oleh mereka yang ada masalah kembung, gastrik ringan atau usus sensitif.
Tiada. Kami gunakan sucralose bebas kalori, iaitu pemanis mesra diabetes dan tidak meningkatkan paras gula dalam darah. Ramai pengguna yang kawal gula memilih Sunnaherbs sebagai alternatif sihat.
Cukup 1 sachet sehari, sebaiknya pada waktu pagi sebelum sarapan. Jika anda perlukan tambahan tenaga atau rasa lebih ringan di waktu petang, boleh ambil satu lagi pada waktu itu.
Ramai pengguna mula rasa perubahan seawal 7–14 hari. Namun kesan optimum biasanya dilihat selepas pengambilan konsisten selama 4 minggu, bergantung pada tahap kesihatan usus masing-masing.
Ya, malah waktu terbaik adalah semasa perut kosong sebelum sarapan supaya nutrien lebih mudah diserap dan bantu sistem usus bersedia untuk proses penghadaman sepanjang hari.
Produk ini bebas bahan berbahaya, namun bagi ibu hamil dan menyusu, kami syorkan rujuk doktor terlebih dahulu sebelum pengambilan.
Tidak. Sunnaherbs Prebiotic Coffee menggunakan biji kopi Arabica rendah asid yang memberi rasa lemak, wangi dan seimbang – tidak pahit dan tidak manis melampau, sesuai untuk peminat kopi sihat.
